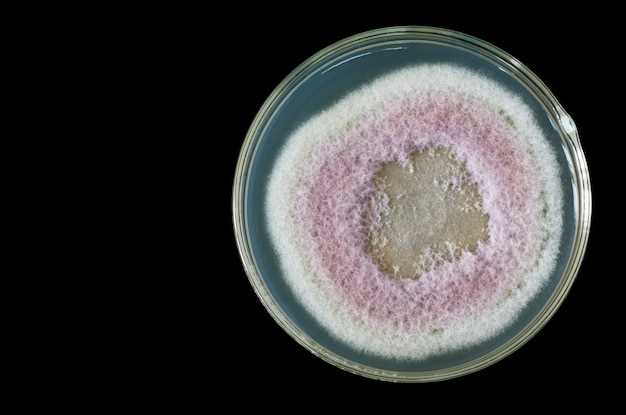
2. Breast enlargement

Finasteride kaskus
2026-02-07Are you tired of dealing with hair loss and thinning hair? It's time to take control and restore your confidence with Finasteride. Kaskus is proud to offer you the best hair loss treatment available on the market today.
Why choose Finasteride?
Finasteride is a proven medication that helps treat hair loss in men by blocking the production of DHT, a hormone that causes hair follicles to shrink and eventually stop producing hair. With Finasteride, you can effectively slow down hair loss, promote hair regrowth, and regain that full head of hair you've been longing for.
The Kaskus advantage
At Kaskus, we understand the impact that hair loss can have on your self-esteem and overall quality of life. That's why we strive to provide you with the highest quality products and exceptional customer service. When you choose Finasteride from Kaskus, you can rest assured that you're making a wise investment in your hair and your happiness.
Take action now!
Don't let hair loss hold you back any longer. It's time to take control and regain your confidence with Finasteride from Kaskus. Place your order today and get on the path to a fuller, thicker head of hair.
Benefits of Finasteride
Finasteride is a medication that provides several benefits when used for the treatment of hair loss and enlarged prostate. Here are some of the key benefits:
Promotes Hair Growth

Finasteride effectively promotes hair regrowth in men who are experiencing male pattern baldness. It works by inhibiting the conversion of testosterone into dihydrotestosterone (DHT), which is a hormone that contributes to hair loss. By reducing DHT levels, Finasteride helps to stimulate hair growth and prevent further hair loss.
Reduces Prostate Enlargement
In addition to its hair growth benefits, Finasteride is also prescribed for the treatment of benign prostatic hyperplasia (BPH), which is a condition characterized by an enlarged prostate gland. By inhibiting the production of DHT, Finasteride helps to shrink the prostate gland, relieving symptoms such as frequent urination, difficulty in starting or stopping urination, and weak urine flow.
Improved Self-Confidence
By promoting hair growth and reducing the size of an enlarged prostate, Finasteride can have a positive impact on a person's self-confidence and overall well-being. Hair loss can often lead to a decrease in self-esteem, and the use of Finasteride can help individuals regain confidence in their appearance.
Note: Finasteride should only be used under the guidance and prescription of a healthcare professional. It is important to discuss any potential side effects or concerns with a doctor before starting this medication.
How Finasteride works
Finasteride is a medication that is commonly used to treat hair loss in men. It works by inhibiting the enzyme 5-alpha reductase, which is responsible for converting testosterone into dihydrotestosterone (DHT) in the body.
DHT is a hormone that plays a key role in hair loss. It binds to the hair follicles, causing them to shrink and eventually stop producing hair. By inhibiting the production of DHT, Finasteride helps to prevent further hair loss and promote hair regrowth.
Blocking DHT
By blocking the production of DHT, Finasteride helps to improve hair follicle health and prolong the hair growth cycle. This allows for thicker and healthier hair to grow.
Finasteride is most effective when taken consistently over a period of time. It is important to note that results may vary from person to person, and it may take several months to see noticeable improvements in hair growth.
Consultation with a healthcare professional
Before starting Finasteride, it is important to consult with a healthcare professional to determine if it is the right treatment option for you. They can assess your individual needs and provide guidance on the appropriate dosage and administration.
It is also important to follow the prescribed dosage and administration instructions carefully to ensure the safe and effective use of Finasteride.
If you experience any side effects while taking Finasteride, it is important to contact your healthcare professional immediately.
Overall, Finasteride is a widely-used and effective medication for the treatment of hair loss in men. By inhibiting the production of DHT, it helps to prevent further hair loss and promote hair regrowth. However, it is important to consult with a healthcare professional before starting Finasteride to ensure it is the right treatment option for you.
Understanding DHT
DHT, or dihydrotestosterone, is a hormone that is derived from testosterone. It plays a crucial role in the development and growth of male reproductive organs, as well as the secondary sexual characteristics in men. However, excess levels of DHT can lead to a variety of problems, including hair loss.
DHT is produced in the body through the conversion of testosterone by an enzyme called 5-alpha reductase. This enzyme is present in various tissues, including the scalp, prostate, and skin. It is the accumulation of DHT in the hair follicles that is primarily responsible for male pattern baldness.
When DHT binds to the hair follicles' androgen receptors, it can lead to a process called miniaturization. This process causes the hair follicles to shrink over time, resulting in shorter and thinner hair strands. Eventually, the hair follicles can become so small that they are unable to produce visible hair, leading to baldness.
Understanding DHT is crucial in addressing hair loss concerns. By inhibiting the production of DHT or minimizing its impact on the hair follicles, individuals can effectively combat hair loss and promote hair regrowth.
Inhibition of DHT
Dihydrotestosterone (DHT) is a hormone that plays a significant role in male pattern hair loss (androgenetic alopecia). It is formed when an enzyme called 5-alpha-reductase converts testosterone into DHT.
Finasteride works by inhibiting the production of 5-alpha-reductase, the enzyme responsible for converting testosterone into DHT. By reducing the levels of DHT in the scalp, Finasteride helps to slow down the miniaturization of hair follicles and prevent further hair loss.
By inhibiting DHT, Finasteride helps to promote hair regrowth and improve hair thickness. It is a clinically proven treatment for male pattern hair loss and has been used by millions of men worldwide.
It is important to note that Finasteride should only be used as directed by a healthcare provider, as there may be potential risks and side effects associated with its use.
If you are considering using Finasteride for hair loss, it is recommended to consult with a healthcare professional to determine the appropriate dosage and to discuss any potential risks or side effects.
Remember: Always speak to a qualified healthcare professional before starting any new treatment or medication.
Finasteride dosage
When it comes to taking Finasteride, it is important to follow the recommended dosage for optimal results. The typical dosage for treating male pattern baldness is 1mg per day, which is a small pill taken orally.
It is important to note that Finasteride should be taken exactly as prescribed by your healthcare provider. Do not take more or less than the prescribed dosage, as it may not be effective or could potentially lead to unwanted side effects.
If you forget to take a dose, do not double up on your next dose. Simply take the missed dose as soon as you remember, and continue with your regular dosing schedule.
It is also worth mentioning that the duration of treatment with Finasteride will vary depending on the individual and the condition being treated. It may take several months to see noticeable results, so it is important to be patient and consistent with your dosage.
Tips for proper administration:
- Take Finasteride at the same time each day to help establish a routine.
- Swallow the pill whole with a glass of water. Do not crush or chew the tablet.
- It can be taken with or without food, but try to take it consistently with your daily meals.
- If you experience any unusual side effects or have concerns about your dosage, consult with your healthcare provider.
By following the recommended dosage and proper administration guidelines, you can maximize the benefits of Finasteride treatment and potentially slow down or even reverse hair loss.
Proper administration
When using Finasteride, it is important to follow the proper administration guidelines to ensure maximum effectiveness and minimize potential side effects. Here are some key points to consider:
1. Consultation with a healthcare professional
Before starting Finasteride, it is recommended to consult with a healthcare professional who can evaluate your individual situation and provide personalized guidance. They will assess your medical history and ensure that Finasteride is a suitable option for you.
2. Recommended dosage
The recommended dosage of Finasteride for treating hair loss is 1mg per day. It is important to take the prescribed amount consistently to maintain a steady presence of the medication in your system.
3. Timing of administration
Finasteride can be taken with or without food, but it is best to take it at the same time each day to help establish a routine. Setting a reminder or incorporating it into your daily routine can help ensure you don't miss a dose.
4. Swallowing the tablet
Finasteride tablets should be swallowed whole with a full glass of water. Do not crush, chew, or break the tablets, as this may alter the way the medication is absorbed by your body.
5. Regular usage
To experience the benefits of Finasteride, it is important to use it regularly. Results may not be immediate and can take several months to become noticeable. Consistency is key for long-term success.
6. Follow-up consultations
While using Finasteride, it is advisable to have regular follow-up consultations with your healthcare professional. They can monitor your progress, evaluate any potential side effects, and make any necessary adjustments to your treatment plan if needed.
Following these guidelines for the proper administration of Finasteride will help maximize its effectiveness and minimize the risk of any unwanted side effects. Remember to consult with a healthcare professional for personalized advice and guidance throughout your treatment journey.
Potential side effects
While finasteride has been proven to be effective in treating hair loss, it is important to be aware of the potential side effects that may occur. Although rare, some individuals may experience adverse reactions when taking finasteride.
1. Sexual side effects
One of the most commonly reported side effects of finasteride is a decrease in libido or sexual desire. Some individuals may also experience erectile dysfunction or a decrease in the volume of ejaculation. These side effects are generally reversible and will go away once the medication is discontinued.
2. Breast enlargement
In some cases, finasteride can cause breast enlargement or tenderness in men. This condition, known as gynecomastia, occurs due to hormonal changes and is generally reversible after stopping the medication.
3. Allergic reactions
In rare cases, individuals may experience allergic reactions such as rash, itching, or swelling of the face, lips, or tongue. If any of these symptoms occur, it is important to seek medical attention immediately.
4. Mood changes
Some individuals have reported changes in their mood while taking finasteride. This can include feelings of depression, anxiety, or irritability. If you notice any significant changes in your mood, it is important to consult with your healthcare provider.
It is important to note that these side effects are rare and may not occur in all individuals taking finasteride. If you have any concerns or questions about the potential side effects, it is recommended to speak with your doctor or pharmacist before starting treatment.
Where to buy Finasteride
If you're interested in purchasing Finasteride, there are a few different options available to you. Here are a few suggestions:
- Pharmacies: Many pharmacies carry Finasteride and may require a prescription from a healthcare professional. Check with your local pharmacy to see if they stock this medication.
- Online pharmacies: There are numerous online pharmacies that offer Finasteride for purchase. It's important to do your research and ensure that you are buying from a reputable source.
- Doctor's office: If you've been prescribed Finasteride, your healthcare provider may have samples or be able to provide you with a prescription directly.
- Specialty clinics: Some specialty clinics or hair loss treatment centers may have Finasteride available for purchase. These facilities often have experts who can provide guidance and answer any questions you may have.
Remember, it's important to speak with a healthcare professional before starting any new medication, including Finasteride. They can provide personalized advice and make sure it's the right choice for you.